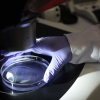
Ученые обнаружили в России новый штамм коронавируса «русский дельтакрон»

www.NazarNews.kg NazarNews - дүйнө назарында! www.NazarNews.kg NazarNews - в центре мирового внимания! www.NazarNews.kg NazarNews - ترى العالم في عينيك www.NazarNews.kg NazarNews - 你眼中的世界! www.NazarNews.kg NazarNews - dünya gözünüzde! www.NazarNews.kg NazarNews - The world in your eyes! www.NazarNews.kg Биздин байланыш: +996 779 028 383 www.NazarNews.kg Email: [email protected] www.NazarNews.kg WhatsApp кабар: +996 779 028 383 www.NazarNews.kg
Разработка позволит заправлять беспилотники в полете в любое время суток в автоматическом режиме
Специалисты Военного учебно-научного центра ВВС «Военно-воздушная академия им. профессора Н. Е. Жуковского и Ю. А. Гагарина» изобрели и запатентовали систему заправки беспилотных летательных аппаратов в полете. Это изобретение позволит производить заправку в любое время года и суток в автоматическом режиме, а пребывание дронов в воздухе будет увеличено, сообщает ТАСС.
«Предлагаемая система позволит производить заправку БЛА топливом в полете в любое время года и суток в автоматическом режиме, повысить надежность и безопасность на этапе стыковки, а в случае ее применения для пилотируемых воздушных судов значительно снизить психофизические нагрузки на экипаж воздушного судна», — сообщается в посвященном изобретению документе Федерального института промышленной собственности. Также ожидается, что новая разработка повысит безопасность и надежность на этапе стыковки конуса беспилотника-заправщика с заправочной штангой заправляемого беспилотника вне зависимости от спутниковой навигационной системы. Для использования изобретения могут применяться штатные средства, входящие в состав бортового радиоэлектронного оборудования воздушных судов, добавили разработчики.
По задумке изобретателей, заправка будет происходить при помощи беспилотника-заправщика, который оснащен заправочным шлангом с установленным конусом, агрегатом заправки, блоком управления, датчиком положения конуса и датчиком стыковки.
Как утверждают разработчики, ближайший аналог изобретения, который был запатентован в США, обладает недостатками по сравнению с их изобретением. Так, он отличается «большими психофизическими нагрузками на пилота самолета-заправщика ввиду отсутствия у него точных координат о взаимном положении конуса и штанги». Также они упомянули, что американская разработка может применяться только при малом расстоянии, что снижает и надежность, и безопасность заправки и делает невозможной заправку в сложных метеоусловиях, особенно в темное время суток.
Первая дозаправка БПЛА в полете была осуществлена в 2015 году боевым беспилотником X-47 Pegasus американской компании Northrop Grumman и заправщиком Omega Air KC-707.
В июне появилась информация о том, что в России разрабатывают беспилотный летательный аппарат палубного базирования. Его первый испытательный полет должен состояться через три года, а эскизное проектирование ударных и разведывательных беспилотников палубного базирования запланировано на вторую половину 2022 года. В 2024 проект должен быть сдан.
Источник: "trtrussian.com"
< Предыдущий
Следующий >

Последние новости